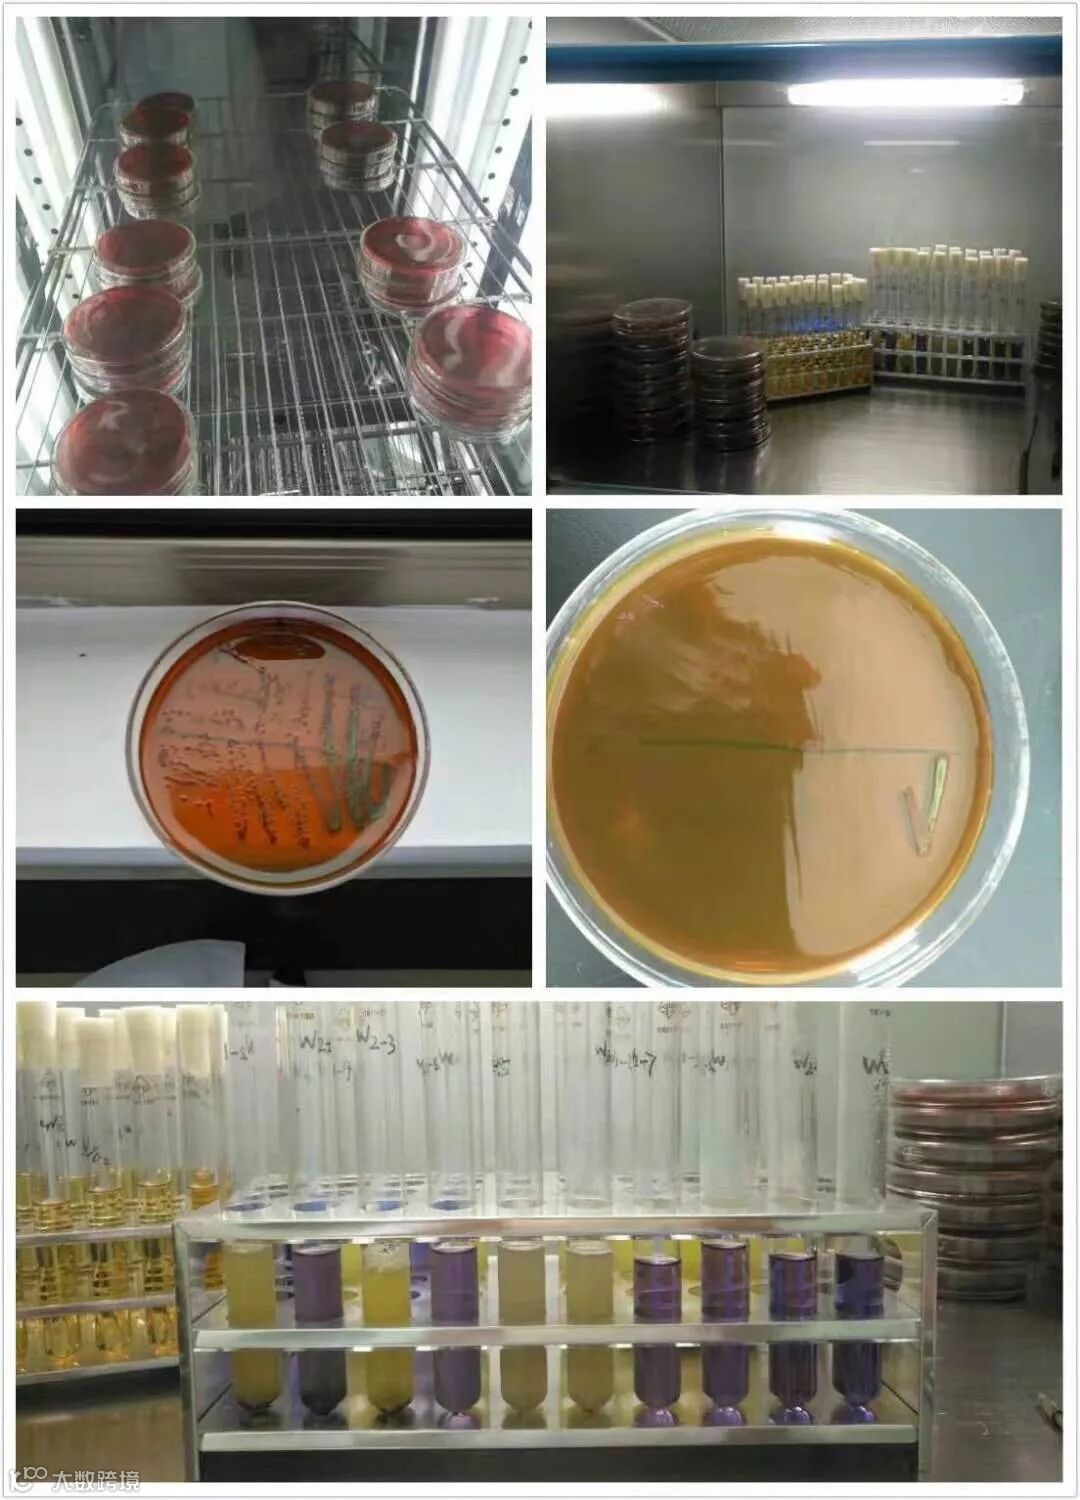

云南顺丰洱海环保科技股份有限公司一直都秉承“质量精益求精,服务尽善尽美”的经营理念,我们的产品从原料进厂到成品出厂都严格遵守“原料进厂100%合格、产品出厂100%合格、定量包装100%合格”的质量管控程序层层把关,绝不出不良品。









为了做到“质量精益求精,服务尽善尽美”的服务理念,公司专门成立了工程技术研究中心、农化服务中心。











我们始终坚信,我们卖的是质量和服务,是我们顺丰洱海环保工作人员的信念!
(顺丰洱海环保股份综合办王隆雲—供稿)


 洱海环保股份
洱海环保股份



云南顺丰洱海环保科技股份有限公司一直都秉承“质量精益求精,服务尽善尽美”的经营理念,我们的产品从原料进厂到成品出厂都严格遵守“原料进厂100%合格、产品出厂100%合格、定量包装100%合格”的质量管控程序层层把关,绝不出不良品。

为了做到“质量精益求精,服务尽善尽美”的服务理念,公司专门成立了工程技术研究中心、农化服务中心。











我们始终坚信,我们卖的是质量和服务,是我们顺丰洱海环保工作人员的信念!
(顺丰洱海环保股份综合办王隆雲—供稿)



